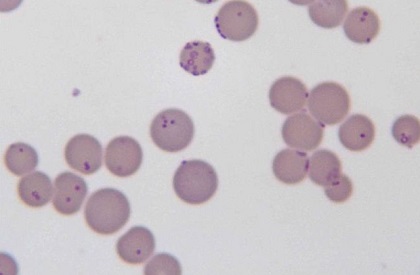

Британские генетики впервые искусственно синтезировали новое живое существо
_____
Британским генетикам удалось впервые в мире синтезировать полностью искусственный живой организм, представляющий собой жизнеспособную бактерию с минимальным набором необходимых для выживания и передачи потомству генов.
Mycoplasma. Фото с сайта wikimedia.org
Mycoplasma. Фото с сайта wikimedia.org
Работы велись под руководством доктора Крейга Вентера, сообщается в журнале Science.
В рамках исследования ученые пытались выяснить, насколько можно сократить геном организма, чтобы не нарушить функциональность базовых систем жизнедеятельности. Для эксперимента была выбрана бактерия Mycoplasma mycoide (известна как главный возбудитель смертельных легочных заболеваний крупного рогатого скота и домашних коз).
Mycoplasma mycoide - это простейшая бактерия, которая не имеет даже жесткой клеточной стенки. Ее геном является едва ли не самым простым из всех известных науке - в нем всего 901 ген. Ученым удалось сократить это число до 437 и таким образом получить новую бактерию, ранее не существовавшую в природе.
Около трети из обнаруженных генов в новом микроорганизме («рабочее» название JCVI-syn3.0) все еще остаются неисследованными, но уже известно, что без них бактерия существовать не может.
По словам Вентера, в будущем, теоретически, манипулируя определенным набором генов, можно будет создать практически любой организм.
- 3678 просмотров
